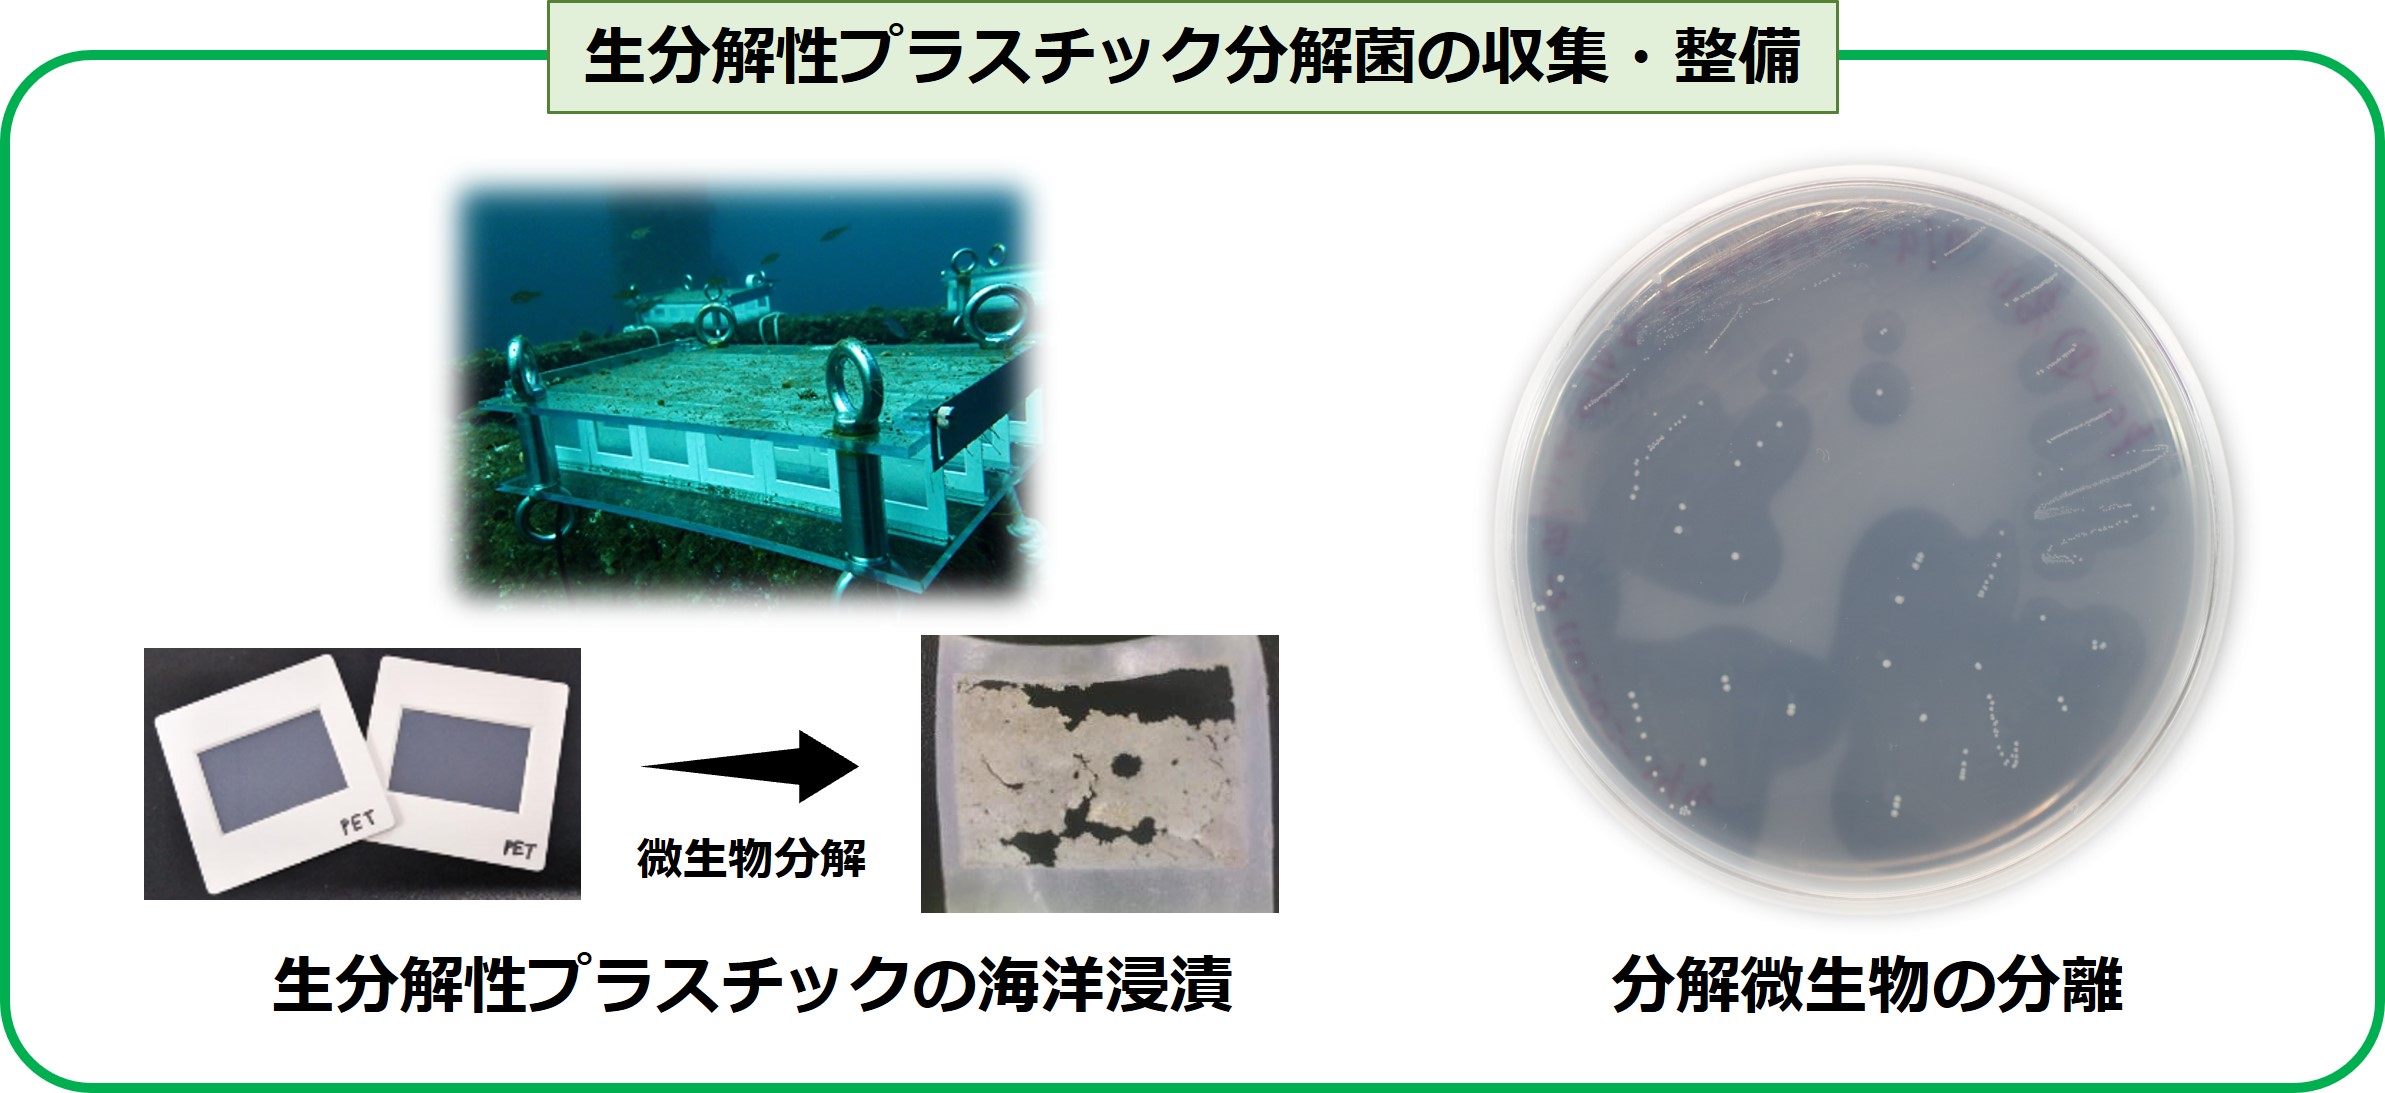
生分解性プラスチック分解菌の収集・整備の図

NITEバイオテクノロジーセンター、生分解性プラスチックの海洋分解微生物20株の提供開始
公表日
2024年5月23日
本件の概要
報道発表資料
- 発表日:
- 令和6年5月23日 (木曜日)
- タイトル:
- NITEバイオテクノロジーセンター、生分解性プラスチックの海洋分解微生物20株の提供開始
~ 海プラごみ問題の解決に向け、新たな海洋生分解性プラスチックの開発や
生分解性評価への活用に貢献 ~ - 発表者名:
- 独立行政法人製品評価技術基盤機構バイオテクノロジーセンター
- 発表の内容:
- 独立行政法人製品評価技術基盤機構[NITE(ナイト)、理事長:長谷川 史彦、本所:東京都渋谷区西原]は、この度、生分解性プラスチックを海洋で分解する微生物20株の提供を開始しました。これまでに分解活性が報告されていなかった新規の微生物も含まれていることから、提供を受けた事業者等がこれらの分解活性や生理性状を調べることで、海洋における生分解性プラスチックの分解機構の解明が進み、新たな海洋生分解性プラスチックの開発や社会実装につながることが期待されます。
-
-
- <背景およびNITEの取組>
- 近年、海洋プラスチックごみ問題が深刻な課題となっています。このため、海洋で完全に分解されるプラスチック(海洋生分解性プラスチック)※1の開発・普及に期待が集まっています。しかし、海洋での生分解性が認められているプラスチックの種類は限られているため、更なる新しい素材の開発が求められています。この開発を促進するためには、海洋における微生物によるプラスチックの分解機構を正しく理解することが重要です。
- NITEは、国立研究開発法人新エネルギー・産業技術総合開発機構(NEDO)のプロジェクト※2において、海洋生分解性プラスチックの分解に関わる微生物の探索や海洋生分解性プラスチックの分解試験法の標準化に向けた取り組みに参画しています。
- このプロジェクトでは、NITEは岩手大学、鹿児島大学、島根大学、広島大学と協力して、各地域の沿岸に3種類(PBSA、PHBH、PCL)の生分解性プラスチックフィルムを浸漬する試験を実施しました※3。そして、フィルムに付着していた微生物の菌叢解析と1万8千株以上の微生物の分離を行い、実海域における生分解性プラスチックの分解に対して重要な役割、可能性を持つ微生物について、その機能を解析しました。
- その結果、NITEはこれまでに報告例のない多くの微生物種が分解活性を有していることを確認し、今回の試験で使用した3種の生分解性プラスチック(PBSA、PHBH、PCL)それぞれに対し、比較的高い分解活性を示したOceaniserpentilla sp. NBRC 116188、Sessilibacer corallicola NBRC 116591、Thalassolituus maritimus NBRC 116585などを含む分解微生物20株の提供を開始しました。
- 本事業の成果は、NBRCのHPよりご確認いただけるほか、今回提供を開始した菌株は、NBRCオンラインカタログからご利用いただけます。
- <海洋プラスチックごみ問題への取り組みについて(NITE)>
https://www.nite.go.jp/nbrc/industry/plastic-waste.html - <NBRC株の分譲(NITE)>
https://www.nite.go.jp/nbrc/cultures/nbrc/order/gene.html -
- <今回のポイントと今後の展望>
- NITEでは菌叢解析や分離した微生物の系統関係を踏まえて選抜した400以上の株について生分解性プラスチックに対する分解活性を測定し、微生物種によって各素材に対する分解活性が異なることも確認しました。
- 今回の実験により、これまでに明らかになっていなかった海洋での生分解性プラスチックの分解菌が特定された他、これまでに報告例のない種を含む、多くの微生物種が海洋で生分解プラスチックの分解に関与している可能性も示唆され、新たな海洋生分解性プラスチックの開発に向けた微生物による分解機構の解明が進むことが期待されます。
- 現在も、NITEでは400以上の分離株について生分解性プラスチックに対する分解活性を測定しており、活性が認められた菌株について順次提供を行っていく予定です。
- NITEは今後も、新たな海洋生分解性プラスチックの開発と社会実装を促進するために、菌株提供に加え、これら分解微生物のゲノム情報や酵素活性等の情報付加も併せて行うことで、海洋における微生物による生分解性プラスチックの分解メカニズムの解明に貢献します。
-
-
- ※1
- 微生物の働きにより最終的には二酸化炭素と水に分解されるプラスチック。
- ※2
- 国立研究開発法人新エネルギー・産業技術総合開発機構「海洋生分解性プラスチックの社会実装に向けた技術開発事業」
- https://www.nedo.go.jp/activities/ZZJP_100168.html
- ※3
- NITE「日本沿岸での生分解性プラスチック浸漬試験から得られた微生物」
- https://www.nite.go.jp/nbrc/industry/plastic-waste/immersion-test/biodegrading-bacteria.html
発表資料
NITEバイオテクノロジーセンター、生分解性プラスチックの海洋分解微生物20株の提供開始
~ 海プラごみ問題の解決に向け、新たな海洋生分解性プラスチックの開発や生分解性評価への活用に貢献 ~
PDFファイルをご覧いただくためには、Adobe Reader(無償)が必要です。Adobe Readerはダウンロードページ![]() よりダウンロードできます。
よりダウンロードできます。
お問い合わせ
- 独立行政法人製品評価技術基盤機構 バイオテクノロジーセンター バイオ技術評価・開発課(かずさ)
-
TEL:0438-20-5764
住所:〒292-0818 千葉県木更津市かずさ鎌足2-5-8 地図
お問い合わせフォームへ








